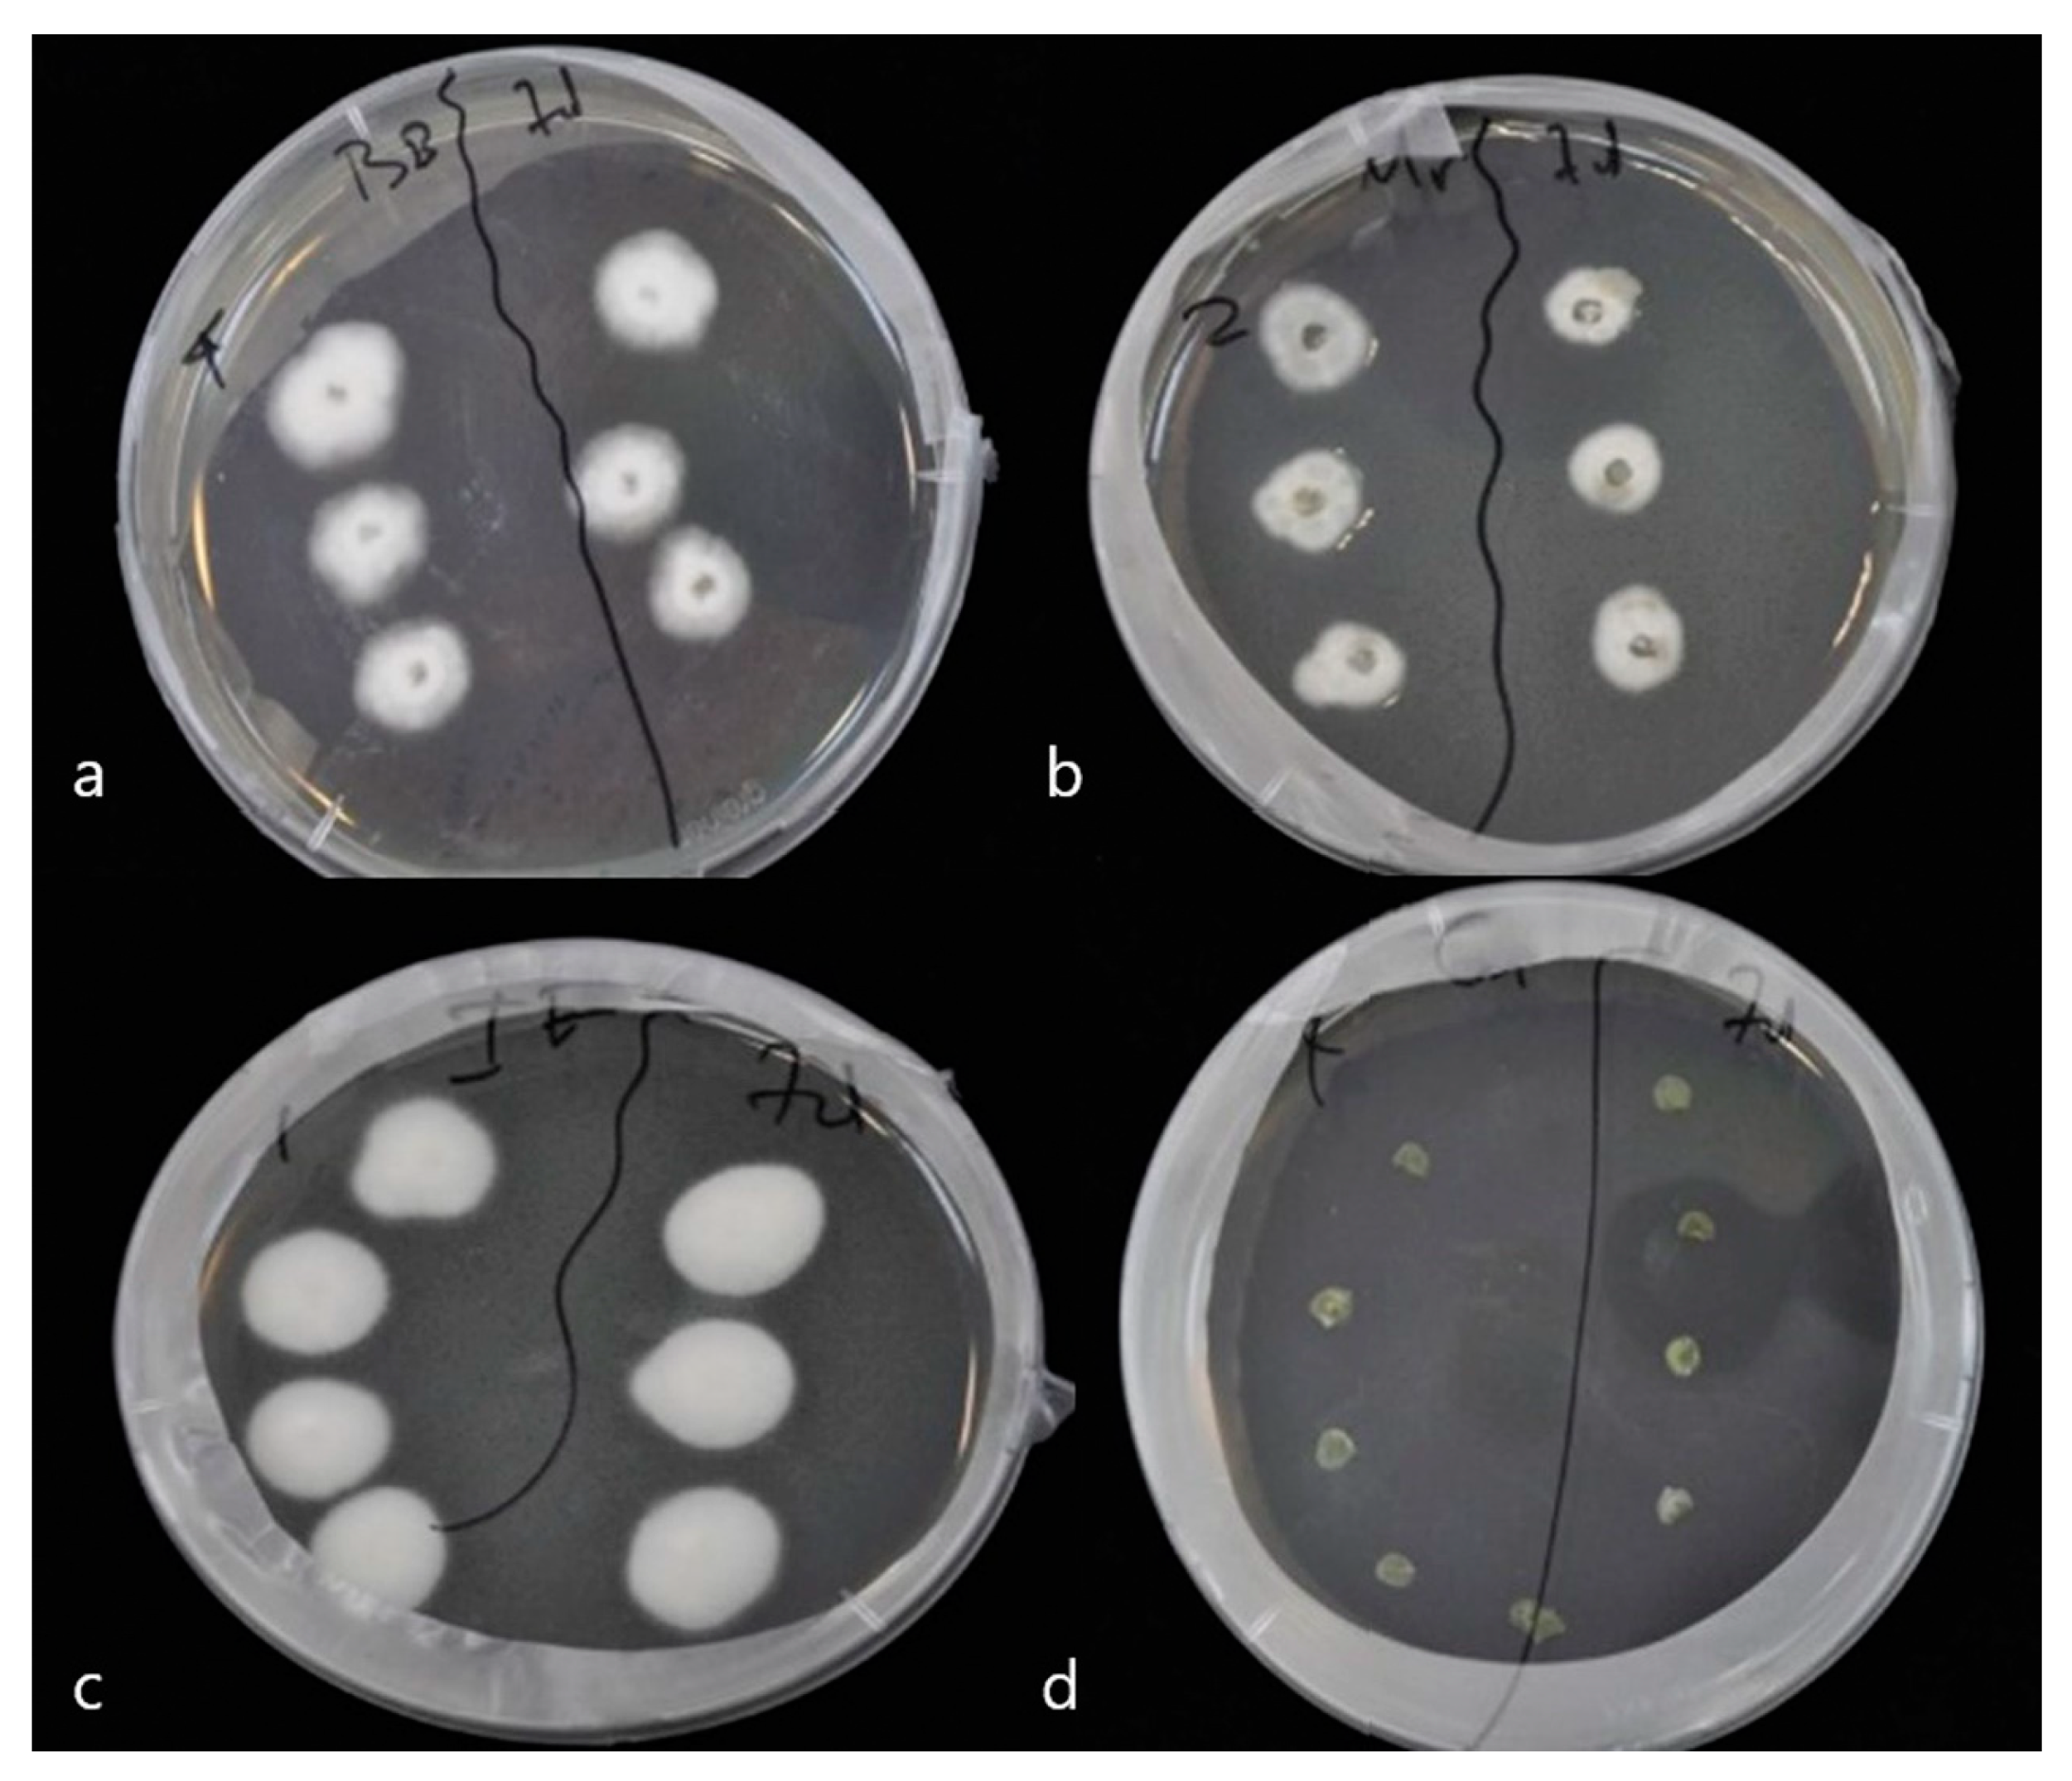

Endophytic Colonization of Pepper (Capsicum annum) Controls Aphids (Myzus persicae Sulzer)
Abstract
:1. Introduction
2. Materials and Methods
2.1. Fungi, Insect and Plant Material
2.2. Plant Inoculation with Fungal Entomopathogens and Assessment of Endophytic Colonization
2.3. Effect of Endophytic Entomopathogenic Fungi on M. persicae
2.4. Determining the Cause of Death of M. persicae
2.5. Statistical Analysis
3. Results
3.1. Re-Isolation of Endophytic Entomopathogenic Fungi from Pepper Leaves on SDA Substrate
3.2. Survival of M. persicae Aphids on Endophytically Colonized Pepper Plants
3.3. Capsicum annum Growth (Height and Number of Leaves)
4. Discussion
5. Conclusions
Author Contributions
Funding
Acknowledgments
Conflicts of Interest
References
- Vega, F.E.; Goettel, M.S.; Blackwell, M.; Chandler, D.; Jackson, M.A.; Keller, S.; Koike, M.; Maniania, N.K.; Monzón, A.; Ownley, B.H.; et al. Fungal entomopathogens: New insights on their ecology. Fungal Ecol. 2009, 2, 149–159. [Google Scholar] [CrossRef]
- Mantzoukas, S.; Chondrogiannis, C.; Grammatikopoulos, G. Effects of three endophytic entomopathogens on sweet sorghum and on the larvae of the stalk borer Sesamia nonagrioides. Entomol. Exp. Appl. 2015, 154, 78–87. [Google Scholar] [CrossRef]
- Vidal, S.; Jaber, L.R. Entomopathogenic fungi as endophytes: Plant-endophyte-herbivore interactions and prospects for use in biological control. Curr. Sci. 2015, 109, 46–54. [Google Scholar]
- Akello, J.; Dubois, T.; Coyne, D.; Kyamanywa, S. Effect of endophytic Beauveria bassiana on populations of the banana weevil, Cosmopolites sordidus, and their damage in tissue-cultured banana plants. Entomol. Exp. Appl. 2008, 129, 157–165. [Google Scholar] [CrossRef]
- Carroll, G. Fungal Endophytes in Stems and Leaves: From Latent Pathogen to Mutualistic Symbiont. Ecology 1988, 69, 2–9. [Google Scholar] [CrossRef]
- Kannadan, S.; Rudgers, J.A. Endophyte symbiosis benefits a rare grass under low water availability. Funct. Ecol. 2008, 22, 706–713. [Google Scholar] [CrossRef]
- Zimmermann, G. The ‘Galleria bait method’ for detection of entomopathogenic fungi in soil. J. Appl. Entomol. 1986, 102, 213–215. [Google Scholar] [CrossRef]
- McKinnon, A.C.; Saari, S.; Moran-Diez, M.E.; Meyling, N.V.; Raad, M.; Glare, T.R. Beauveria bassiana as an endophyte: A critical review on associated methodology and biocontrol potential. BioControl 2017, 62, 1–17. [Google Scholar] [CrossRef]
- Bing, L.A.; Lewis, L.C. Temporal relationships between Zea mays, Ostrinia nubilalis (Lep.: Pyralidae) and endophytic Beauveria bassiana. Entomophaga 1992, 37, 525–536. [Google Scholar] [CrossRef]
- Bing, L.A.; Lewis, L.C. Endophytic Beauveria bassiana (balsamo) vuillemin in corn: The influence of the plant growth stage and Ostrinia nubilalis (hübner). Biocontrol Sci. Technol. 1992, 2, 39–47. [Google Scholar] [CrossRef]
- Wagner, B.L.; Lewis, L.C. Colonization of corn, Zea mays, by the entomopathogenic fungus Beauveria bassiana. Appl. Environ. Microbiol. 2000, 66, 3468–3473. [Google Scholar] [CrossRef]
- Yan, J.F.; Broughton, S.J.; Yang, S.L.; Gange, A.C. Do endophytic fungi grow through their hosts systemically? Fungal Ecol. 2015, 13, 53–59. [Google Scholar] [CrossRef]
- Eastop, V.F. Worlwide Importance of Aphids as Virus Vectors. In Aphids as Virus Vectors; Harris, K.F., Maramorosch, K., Eds.; Academic Press: New York, NY, USA, 1977; pp. 3–62. [Google Scholar]
- Manoussopoulos, Y.; Mantzoukas, S.; Lagoyiannis, I.; Goudoudaki, S. Colonization of pepper by three entomopathogenic fungi and effect on the probing behavior of green peach aphid. In Proceedings of the XVIth EUCARPIA Capsicum and Eggplant Working Group Meeting in Memoriam Dr. Alain Palloix, Kecskemét, Hungary, 12–14 September 2016; pp. 364–368. [Google Scholar]
- Goettel, M.S.; Inglis, G.D. Fungi: Hyphomycetes. In Manual of Techniques in Insect Pathology; Lacey, L.A., Ed.; Academic Press: San Diego, CA, USA, 1997; pp. 213–249. [Google Scholar]
- Quesada-Moraga, E.; Navas-Cortes, J.A.; Maranhao, A.A.; Ortiz-Urquiza, A.; Santiago-Alvarez, C. Factors affecting the occurrence and distribution of entomopathogenic fungi in natural and cultivated soils. Mycol. Res. 2007, 111, 947–966. [Google Scholar] [CrossRef] [PubMed]
- Gurulingappa, P.; Sword, G.A.; Murdoch, G.; McGee, P.A. Colonization of crop plants by fungal entomopathogens and their effects on two insect pests when in planta. Biol. Control 2010, 55, 34–41. [Google Scholar] [CrossRef]
- Rodriguez, R.J.; White, J.F., Jr.; Arnold, A.E.; Redman, R.S. Fungal endophytes: Diversity and functional roles. New Phytol. 2009, 182, 314–330. [Google Scholar] [CrossRef] [PubMed]
- Rogers, S.O.; Bendich, A.J. Extraction of DNA from milligram amounts of fresh, herbarium and mummified plant tissues. Plant Mol. Biol. 1985, 5, 69–76. [Google Scholar] [CrossRef]
- Abbott, W.S. A Method of Computing the Effectiveness of an Insecticide. J. Econ. Entomol. 1925, 18, 265–267. [Google Scholar] [CrossRef]
- Ownley, B.H.; Griffin, M.R.; Klingeman, W.E.; Gwinn, K.D.; Moulton, J.K.; Pereira, R.M. Beauveria bassiana: Endophytic colonization and plant disease control. J. Invertebr. Pathol. 2008, 98, 267–270. [Google Scholar] [CrossRef]
- Ownley, B.H.; Gwinn, K.D.; Vega, F.E. Endophytic fungal entomopathogens with activity against plant pathogens: Ecology and evolution. BioControl 2010, 55, 113–128. [Google Scholar] [CrossRef]
- Akello, J.; Sikora, R. Systemic acropedal influence of endophyte seed treatment on Acyrthosiphon pisum and Aphis fabae offspring development and reproductive fitness. Biol. Control. 2012, 61, 215–221. [Google Scholar] [CrossRef]
- Pelizza, S.A.; Mariottini, Y.; Russo, L.M.; Vianna, M.F.; Scorsetti, A.C.; Lange, C.E. Beauveria bassiana (Ascomycota: Hypocreales) introduced as an endophyte in corn plants and its effects on consumption, reproductive capacity, and food preference of Dichroplus maculipennis (Orthoptera: Acrididae: Melanoplinae). J. Insect Sci. 2017, 17, 1–6. [Google Scholar] [CrossRef]
- Jaber, L.R.; Vidal, S. Fungal endophyte negative effects on herbivory are enhanced on intact plants and maintained in a subsequent generation. Ecol. Entomol. 2010, 35, 25–36. [Google Scholar] [CrossRef]
- Kuldau, G.; Bacon, C. Clavicipitaceous endophytes: Their ability to enhance resistance of grasses to multiple stresses. Biol. Control 2008, 46, 57–71. [Google Scholar] [CrossRef]
- Lopez, C.D.; Zhu-Salzman, K.; Ek-Ramos, J.M.; Sword, G.A. The Entomopathogenic Fungal Endophytes Purpureocillium lilacinum (Formerly Paecilomyces lilacinus) and Beauveria bassiana Negatively Affect Cotton Aphid Reproduction under Both Greenhouse and Field Conditions. PLoS ONE 2014, 9, e103891. [Google Scholar]
- Bing, L.A.; Lewis, L.C. Suppression of Ostrinia nubilalis (Hübner) (Lepidoptera: Pyralidae) by endophytic Beauveria bassiana (Balsamo) Vuillemin. Environ. Entomol. 1991, 20, 1207–1211. [Google Scholar] [CrossRef]
- Posada, F.; Vega, F.E. Establishment of the fungal entomopathogen Beauveria bassiana (Ascomycota: Hypocreales) as an endophyte in cocoa seedlings (Theobroma cacao). Mycologia 2005, 97, 1195–1200. [Google Scholar] [CrossRef] [PubMed]
- Posada, F.; Vega, F.E. Inoculation and colonization of coffee seedlings (Coffea arabica L.) with the fungal entomopathogen Beauveria bassiana (Ascomycota: Hypocreales). Mycoscience 2006, 47, 284–289. [Google Scholar] [CrossRef]
- Gómez-Vidal, S.; Lopez-Llorca, L.V.; Jansson, H.-B.; Salinas, J. Endophytic colonization of date palm (Phoenix dactylifera L.) leaves by entomopathogenic fungi. Micron 2006, 37, 624–632. [Google Scholar]
- Tefera, T.; Vidal, S. Effect of inoculation method and plant growth medium on endophytic colonization of sorghum by the entomopathogenic fungus Beauveria bassiana. BioControl 2009, 54, 663–669. [Google Scholar] [CrossRef]
- Arab, Y.A.; El-Deeb, H.M. The use of endophyte Beauveria bassiana for bio-protection of date palm seedlings against red palm weevil and rhizoctonia root-rot disease. Sci. J. King Faisal Univ. (Basic Appl. Sci.) 2012, 13, 91–101. [Google Scholar]
- Batta, Y.A. Efficacy of endophytic and applied Metarhizium anisopliae (Metch.) Sorokin (Ascomycota: Hypocreales) against larvae of Plutella xylostella L. (Yponomeutidae: Lepidoptera) infesting Brassica napus plants. Crop Prot. 2013, 44, 128–134. [Google Scholar] [CrossRef]
- Landa, B.B.; López-Díaz, C.; Jiménez-Fernández, D.; Montes-Borrego, M.; Muñoz-Ledesma, F.J.; Ortiz-Urquiza, A.; Quesada-Moraga, E. In-planta detection and monitorization of endophytic colonization by a Beauveria bassiana strain using a new-developed nested and quantitative PCR-based assay and confocal laser scanning microscopy. J. Invertebr. Pathol. 2013, 114, 128–138. [Google Scholar] [CrossRef] [PubMed]
- Ramirez-Rodriguez, D.; Sánchez-Peña, S.R. Endophytic Beauveria bassiana in Zea mays: Pathogenicity against Larvae of Fall Armyworm, Spodoptera frugiperda. Southwest. Entomol. 2016, 41, 875–878. [Google Scholar] [CrossRef]
- Ramírez-Rodríguez, D.; Sánchez-Peña, S.R. Recovery of endophytic Beauveria bassiana on a culture medium based on cetyltrimethylammonium bromide. Biocontrol Sci. Technol. 2016, 26, 570–575. [Google Scholar] [CrossRef]
- Jaber, L.R.; Araj, S.-E. Interactions among endophytic fungal entomopathogens (Ascomycota: Hypocreales), the green peach aphid Myzus persicae Sulzer (Homoptera: Aphididae), and the aphid endoparasitoid Aphidius colemani Viereck (Hymenoptera: Braconidae). Biol. Control. 2018, 116, 53–61. [Google Scholar] [CrossRef]
- Powell, W.A.; Klingeman, W.E.; Ownley, B.H.; Gwinn, K.D. Evidence of Endophytic Beauveria bassiana in Seed-treated Tomato Plants Acting as a Systemic Entomopathogen to Larval Helicoverpa zea (Lepidoptera: Noctuidae). J. Entomol. Sci. 2009, 44, 391–396. [Google Scholar] [CrossRef]
- Russo, M.L.; Pelizza, S.A.; Vianna, M.F.; Allegrucci, N.; Cabello, M.N.; Toledo, A.V.; Mourelos, C.; Scorsetti, A.C. Effect of endophytic entomopathogenic fungi on soybean Glycine max (L.) Merr. growth and yield. J. King Saud Univ. - Sci. (in press)
- Griffin, M.R.; Ownley, B.H.; Klingeman, W.E.; Pereira, R.M. Biocontrol of Rhizoctonia damping-off of cotton with endophytic Beauveria bassiana. Phytopathology 2005, 95, S36. [Google Scholar]
- Ownley, B.H.; Pereira, R.M.; Klingeman, W.E.; Quigley, N.B.; Leckie, B.M. Beauveria bassiana, a dual purpose biocontrol organism, with activity against insect pests and plant pathogens. In Emerging Concepts in Plant Health Management; Lartey, R.T., Cesar, A.J., Eds.; Research Signpost: Thiruvananthapuram, India, 2004; pp. 255–269. [Google Scholar]
- Lopez, D.C.; Sword, G.A. The endophytic fungal entomopathogens Beauveria bassiana and Purpureocillium lilacinum enhance the growth of cultivated cotton (Gossypium hirsutum) and negatively affect survival of the cotton bollworm (Helicoverpa zea). Biol. Control 2015, 89, 53–60. [Google Scholar] [CrossRef]
- Greenfield, M.; Gómez-Jiménez, M.I.; Ortiz, V.; Vega, F.E.; Kramer, M.; Parsa, S. Beauveria bassiana and Metarhizium anisopliae endophytically colonize cassava roots following soil drench inoculation. Biol. Control 2016, 95, 40–48. [Google Scholar] [CrossRef]
- Qayyum, M.A.; Wakil, W.; Arif, M.J.; Sahi, S.T.; Dunlap, C.A. Infection of Helicoverpa armigera by endophytic Beauveria bassiana colonizing tomato plants. Biol. Control 2015, 90, 200–207. [Google Scholar] [CrossRef]

| Treatment | Day after Exposure (DAE) | Proportion Terminating * (%) | Proportion Surviving ** (%) | Cumulative Proportion Surviving at End of Interval *** (% ± sd) | Hazard Rate **** (% ± sd) |
|---|---|---|---|---|---|
| B. bassiana plants | 0 | 57 | 43 | 100 | 00 |
| 7 | 100 | 00 | 43 ± 09 | 11 ± 03 | |
| 14 | 00 | 100 | 00 | 29 | |
| M. anisopliae plants | 0 | 27 | 73 | 100 | 00 |
| 7 | 55 | 45 | 73 ± 08 | 04 ± 02 | |
| 14 | 82 | 18 | 33 ± 09 | 11 ± 03 | |
| 21 | 00 | 100 | 06 ± 05 | 00 | |
| I. fumosorosea plants | 0 | 37 | 63 | 100 | 00 |
| 7 | 53 | 47 | 63 ± 09 | 06 ± 02 | |
| 14 | 62 | 38 | 30 ± 08 | 10 ± 03 | |
| 21 | 00 | 100 | 12 ± 07 | 00 | |
| Control plants | 0 | 00 | 100 | 100 | 00 |
| 7 | 00 | 100 | 100 | 00 | |
| 14 | 00 | 100 | 100 | 00 | |
| 21 | 00 | 100 | 100 | 00 |
© 2019 by the authors. Licensee MDPI, Basel, Switzerland. This article is an open access article distributed under the terms and conditions of the Creative Commons Attribution (CC BY) license (http://creativecommons.org/licenses/by/4.0/).
Share and Cite
Mantzoukas, S.; Lagogiannis, I. Endophytic Colonization of Pepper (Capsicum annum) Controls Aphids (Myzus persicae Sulzer). Appl. Sci. 2019, 9, 2239. https://doi.org/10.3390/app9112239
Mantzoukas S, Lagogiannis I. Endophytic Colonization of Pepper (Capsicum annum) Controls Aphids (Myzus persicae Sulzer). Applied Sciences. 2019; 9(11):2239. https://doi.org/10.3390/app9112239
Chicago/Turabian StyleMantzoukas, Spiridon, and Ioannis Lagogiannis. 2019. "Endophytic Colonization of Pepper (Capsicum annum) Controls Aphids (Myzus persicae Sulzer)" Applied Sciences 9, no. 11: 2239. https://doi.org/10.3390/app9112239
APA StyleMantzoukas, S., & Lagogiannis, I. (2019). Endophytic Colonization of Pepper (Capsicum annum) Controls Aphids (Myzus persicae Sulzer). Applied Sciences, 9(11), 2239. https://doi.org/10.3390/app9112239
